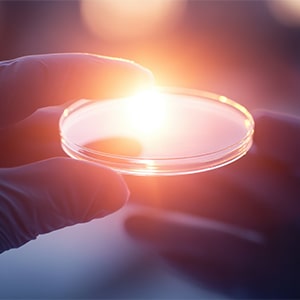
Close-up of a gloved hand holding a Petri dish with a glowing surface in a laboratory setting

.jpg)
Expert Consulting for Complex Healthcare Research
Navigate challenging research questions with confidence.
Our experienced consultants provide strategic guidance, methodological expertise, and practical solutions tailored to your specific needs, ensuring your projects meet the highest standards of scientific rigor.
Strategic Consulting Services for Complex Research Challenges
Our consulting services provide organizations with expert guidance tailored to their unique research needs. We ensure that your projects are de
igned and executed to the highest standards, enhancing scientific rigor and regulatory compliance.
Expert guidance for complex research challenges.
Achieve research objectives through strategic expertise.


Unlocking Success: The Power of Expert Consulting in Complex Healthcare Research
Expert consulting services are crucial for navigating complex research challenges and achieving scientific objectives.
By providing strategic guidance and methodological expertise, they empower organizations to overcome obstacles and deliver high-impact studies that advance healthcare knowledge.
Driving Impact Through Evidence-Based Systematic Reviews
Our commitment to excellence is grounded in proven results and extensive experience:
Partner with The Health & Evidence Company to leverage our decades of expertise and empower your decisions with the best available healthcare evidence.
Publications delivered
Providing trusted, evidence-based information to healthcare stakeholders worldwide.

Years in the industry
A legacy of advancing healthcare through rigorous research and expert consulting.

Analyses conducted
Executing high-quality systematic reviews and meta-analyses that elevate research standards.